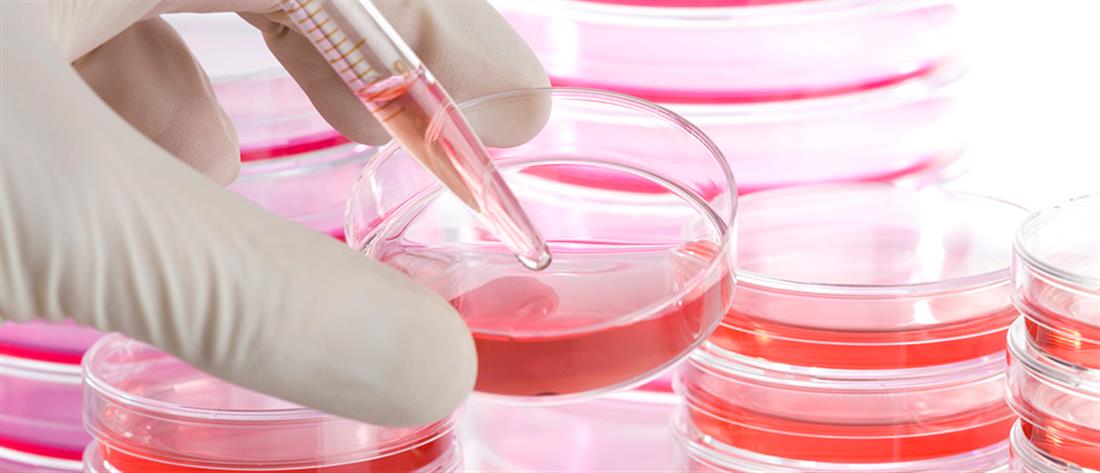

Τεχνολογία
Καρκίνος: εμβόλιο mRNA εξάλειψε τους όγκους σε ποντίκια
Το πειραματικό εμβόλιο κατά του καρκίνου εξαλείφει τους όγκους και αποτρέπει την επανεμφάνισή τους, σε ποντίκια με μεταστατικό μελάνωμα.

Ερευνητές στο Πανεπιστήμιο Tufts στη Μασαχουσέτη των ΗΠΑ, ανέπτυξαν μια μέθοδο στόχευσης του καρκίνου με ένα εμβόλιο mRNA που εξαλείφει τους όγκους και αποτρέπει την επανεμφάνισή τους, σε ποντίκια.
Το πειραματικό εμβόλιο λειτουργεί περίπου όπως και τα εμβόλια κατά της Covid-19 της Pfizer και της Moderna, τα οποία ενσωματώνουν mRNA σε μικροσκοπικές φυσαλίδες λιπιδίων που τελικά συγχωνεύονται με τα κύτταρα του σώματος, επιτρέποντας στα κύτταρα να «διαβάσουν» το mRNA και να παράγουν ιικά αντιγόνα, τα οποία είναι μικροσκοπικά θραύσματα του ιού που ενεργοποιούν το ανοσοποιητικό σύστημα.
Το mRNA κωδικοποιεί αντιγόνα που υπάρχουν στα καρκινικά κύτταρα, και οι φυσαλίδες, γνωστές ως λιπιδικά νανοσωματίδια (LNP), μπορούν να στοχεύουν το λεμφικό σύστημα, όπου τα ανοσοποιητικά κύτταρα «εκπαιδεύονται», καθιστώντας την απόκριση πολύ πιο αποτελεσματική.
«Αναπτύσσουμε την επόμενη γενιά mRNA εμβολίων χρησιμοποιώντας την τεχνολογία μεταφοράς λιπιδικών νανοσωματιδίων, με τη δυνατότητα να στοχεύουν συγκεκριμένα όργανα και ιστούς», δήλωσε ο Qiaobing Xu, ένας από τους συγγραφείς της μελέτης και καθηγητής βιοϊατρικής μηχανικής στο Πανεπιστήμιο Tufts.
«Η στόχευση του λεμφικού συστήματος μας βοήθησε να ξεπεράσουμε πολλές από τις προκλήσεις που αντιμετώπισαν άλλοι στην ανάπτυξη ενός εμβολίου κατά του καρκίνου», εξήγησε ο ερευνητής.
Μέχρι στιγμής έχουν γίνει περισσότερες από 20 δοκιμές mRNA εμβολίων κατά του καρκίνου. Ωστόσο, έχει παρατηρηθεί ότι μεγάλο μέρος του mRNA καταλήγει στο ήπαρ, οπότε παραμένει ο κίνδυνος φλεγμονής και βλάβης του ήπατος.
Οι ερευνητές του Tufts τροποποίησαν τη χημική δομή των λιπιδίων που σχηματίζουν τις φυσαλίδες, μέχρι να βρουν έναν συνδυασμό που να πηγαίνει στο όργανο-στόχος. Ανακάλυψαν ένα LNP που συγκεντρώθηκε στους λεμφαδένες μετά την υποδόρια έγχυση σε ποντίκια. Οι ερευνητές εκτιμούν πως τα LNP συλλέγουν μόρια από την κυκλοφορία του αίματος στην επιφάνειά τους και πως αυτά τα επιλεγμένα μόρια δεσμεύονται σε συγκεκριμένους υποδοχείς στο όργανο-στόχο.
Ανακάλυψαν επίσης, ότι τα λιπιδικά νανοσωματίδια που χρησιμοποιήθηκαν στο εμβόλιο κατά της Covid-19 της Pfizer, ευνοούσαν την παράδοση στο ήπαρ αντί για το λεμφικό σύστημα, με αναλογία τέσσερα προς ένα. Οι ερευνητές το αντέστρεψαν αυτό, ώστε τα νέα νανοσωματίδια να προτιμούν τη λεμφική παράδοση, με αναλογία τρία προς ένα.
Τα ποντίκια με μεταστατικό μελάνωμα που υποβλήθηκαν σε θεραπεία με το εμβόλιο που στόχευε τους λεμφαδένες, παρουσίασαν σημαντική αναστολή των όγκων και 40% ποσοστό πλήρους ανταπόκρισης, χωρίς υποτροπή μακροπρόθεσμα.
«Τα εμβόλια κατά του καρκίνου αποτελούσαν πάντα μια πρόκληση, επειδή τα αντιγόνα των όγκων δεν φαίνονται πάντα τόσο ‘ξένα’ όπως τα αντιγόνα των ιών και των βακτηρίων, και οι όγκοι μπορούν να αναστείλουν ενεργά την ανοσολογική απόκριση», δήλωσε η Jinjin Chen, ερευνήτρια στο Πανεπιστήμιο Tufts και μέλος της ερευνητικής ομάδας του Xu.
«Αυτό το εμβόλιο κατά του καρκίνου προκαλεί πολύ ισχυρότερη απόκριση και είναι ικανό να μεταφέρει mRNA τόσο για μεγάλα όσο και για μικρά αντιγόνα», εξήγησε η Chen.
«Ελπίζουμε ότι θα μπορούσε να γίνει μια καθολική πλατφόρμα όχι μόνο για εμβόλια κατά του καρκίνου αλλά και για πιο αποτελεσματικά εμβόλια κατά ιών και άλλων παθογόνων», πρόσθεσε.
Ξάνθη: Φωτιά και εκρήξεις σε πολυκατοικία (εικόνες)
Μενέντεζ για Τουρκία: η αγορά νέων S-400 είναι παραβίαση των κυρώσεων
Νέα Ζηλανδία: Λείψανα παιδιών σε βαλίτσες που πουλήθηκαν σε δημοπρασία!
Ακολουθήστε το antenna.gr στο Google News και μάθετε πρώτοι όλες τις ειδήσεις!

